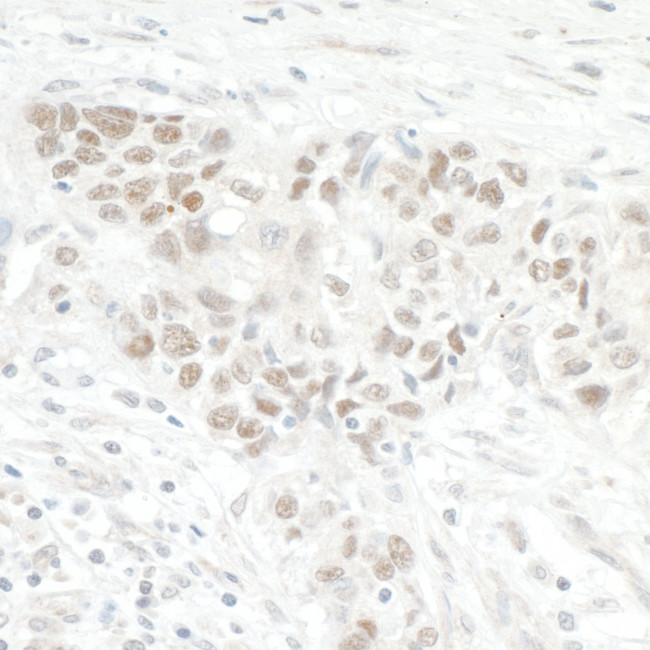
NOL12 Antibody in Immunohistochemistry (Paraffin) (IHC (P))

Search
Bethyl Laboratories
NOL12 Polyclonal Antibody
{{$productOrderCtrl.translations['antibody.pdp.commerceCard.promotion.promotions']}}
{{$productOrderCtrl.translations['antibody.pdp.commerceCard.promotion.viewpromo']}}
{{$productOrderCtrl.translations['antibody.pdp.commerceCard.promotion.promocode']}}: {{promo.promoCode}} {{promo.promoTitle}} {{promo.promoDescription}}. {{$productOrderCtrl.translations['antibody.pdp.commerceCard.promotion.learnmore']}}



Please note: We are reviewing Western blot images included in the antibody testing data in our catalog, including those provided by third parties. Unless expressly labeled or annotated as “raw-unedited”, Western blot images included in the antibody testing data in our catalog may have been edited, optimized or otherwise adjusted for presentation.
产品信息
A302-733A
种属反应
宿主/亚型
分类
类型
抗原
偶联物
形式
浓度
规格
纯化类型
保存液
内含物
保存条件
运输条件
产品详细信息
The recommended shelf life for this product is 1 year from date of receipt.
Application Note: For IHC, epitope retrieval with citrate buffer pH 6.0 is recommended for FFPE tissue sections.
靶标信息
Nop25 is a nucleolar protein predominantly involved in the architecture and function of the nucleolus, which is the cellular hub for ribosomal RNA (rRNA) synthesis and ribosome assembly. It is identified as a putative RNA-binding protein and plays a crucial role in rRNA transcription. Nop25 has been characterized through molecular cloning, showing its ability to bind single-stranded nucleic acids directly. Experimental studies, such as those involving mouse embryogenesis, have utilized techniques like RT-PCR to analyze Nop25's gene expression across developmental stages. Moreover, research on the protein's structure has unveiled its nuclear and nucleolar targeting sequences, vital for its localization to the nucleolus. Treatment of cells with RNase A has illustrated the dissociation of Nop25 from the nucleolus, further highlighting its RNA-binding capabilities. This protein's functional importance is underscored by its role in maintaining nucleolar architecture, as demonstrated by experiments where overexpression of Nop25's N-terminal amino acids disrupted nucleolar integrity.
仅用于科研。不用于诊断过程。未经明确授权不得转售。
篇参考文献 (0)
生物信息学
蛋白别名: 25 kDa nucleolar protein; Nucleolar protein 12; Nucleolar protein of 25 kDa
基因别名: C78541; NOL12; Nop25
UniProt ID: (Mouse) Q8BG17
Entrez Gene ID: (Mouse) 97961